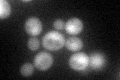
YFL010C
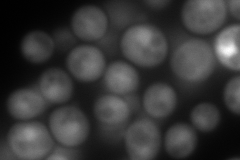
YFL010C
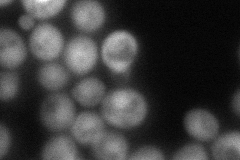
YFL010C
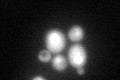
YFL010C
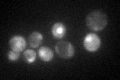
YFL010C

View description
WW domain containing protein of unknown function; binds to Mca1p, a caspase-related protease that regulates H2O2-induced apoptosis; overexpression causes Gi phase growth arrest and clonal death that is suppressed by overexpression of MCA1
Localization:
Intensity:
Fold change:
Significance:
-
C’ GFP library in SD
nucleus:cytosol60.94 -
N' NOP1pr-GFP in SD

cytosol,nucleus290.437 -
N' TEF2pr-mCherry in SD
nucleus322.917 -
N' NATIVEpr-GFP in SD
nucleus67.8597 -
N' TEF2pr-VC and Cyto-VN in SD

below threshold22.7399 -
C’ GFP library in SD+DTT
nucleus.cytosol70.581.15No -
C’ GFP library in SD+H2O2

nucleus.cytosol54.560.89No -
C’ GFP library in Starvation Media
nucleus,cytosol110.531.81Yes -
C’ GFP library on the background of Pup2-DaMP

nucleus:cytosol -
C’ GFP library on the background of CCT mutant

nucleus:cytosol60.49060.992422No
